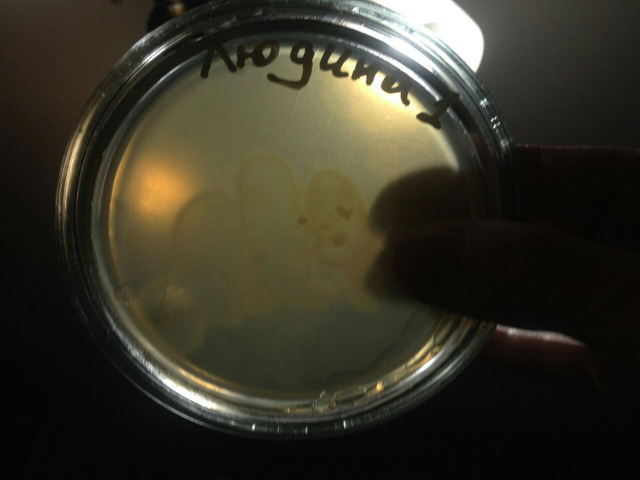
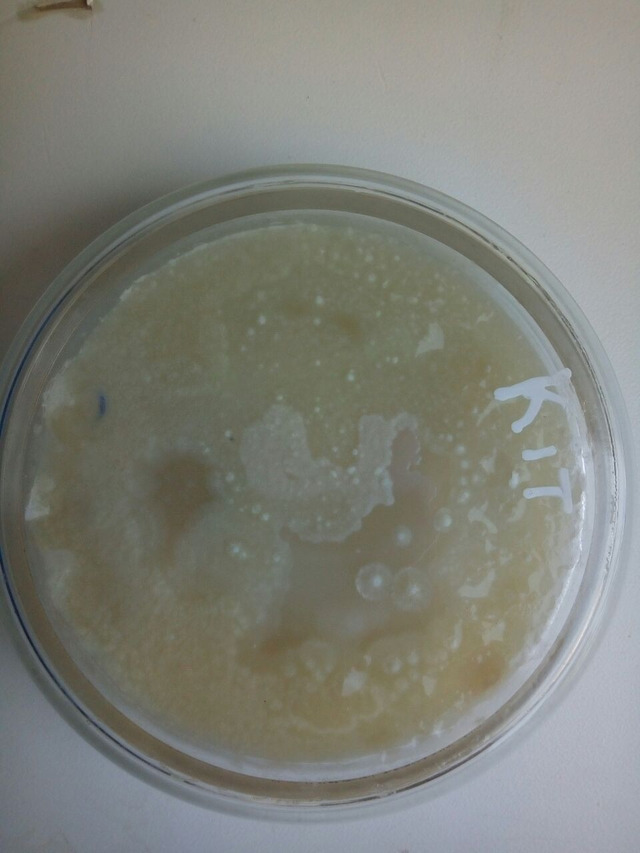
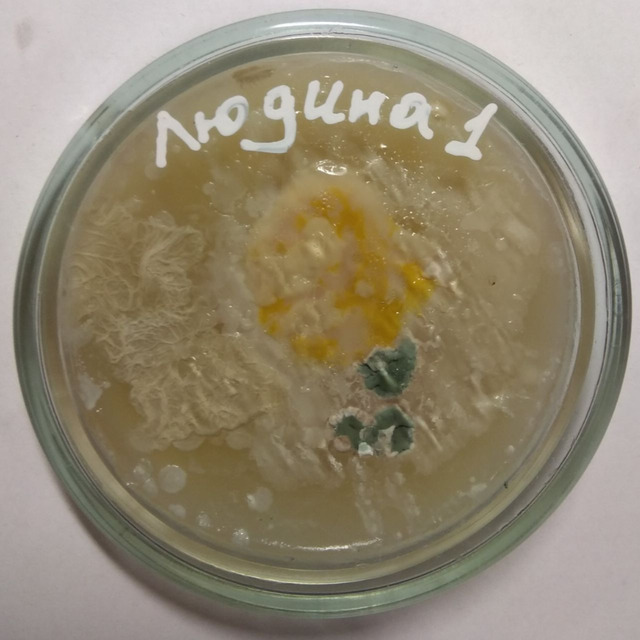

Карантин 2020: ставлення студентів та викладачів. Дистанційне навчання, яке справді зацікавлює
Весна 2020 року стала для світу неабияким випробуванням. COVID-19… Складно знайти людину, яка не чула б про цей вірус. Станом на 6 квітня статистика в світі виглядає так:
Coronavirus Cases: 1 274 022
Deaths: 69 464
Recovered: 264 807
За даними МОЗ, в Україні вже 1319 підтверджений випадок COVID-19, з них летальних — 38, 28 пацієнтів одужали.. За добу було зафіксовано 68 нових випадків.. (https://moz.gov.ua)
Статистика коронавирусу по топ-10 країнам
(дані про нові випадки наведені за добу https://focus.ua/world/453251)

До 24 квітня в Україні оголошено карантин. З 12 березня студенти НУБіП України навчаються в дистанційному режимі. З тих пір студенти під керівництвом своїх викладачів опрацьовують лекційний і практичний матеріал на ресурсі https://elearn.nubip.edu.ua. Сприяє навчанню і відеозв’язок через різні платформи, які використовують викладачі кафедри філософії гуманітарно-педагогічного факультету. Завдяки цьому, навіть в умовах самоізоляції, студенти мають можливість підтримувати повноцінне активне спілкування зі своїми викладачами.
Керівництво, викладачі та студенти нашого університету, беззаперечно, підтримують заходи щодо призупинення поширення вірусу.
«Вже на сьогодні стало зрозумілим, що найкращий механізм профілактики розповсюдження інфекції – це індивідуальна соціальна дистанція, і, на жаль, це дуже складно в умовах університету. Ми повністю розуміємо, що ці зміни призведуть до перебоїв у повсякденному житті тому закликаємо Вас бути взаємно відповідальними перед собою, своїми сім’ями, друзями, членами колективів..», – наголошує ректор НУБіП України Станіслав Ніколаєнко.
«Наше суспільство повинно навчитись жити в новій реальності інфекційних та інформаційних загроз. Жорстке дотримання нових правил гри, як на особистому, так і на державному рівні, сприятиме швидкій адаптації до сучасних, часто неочікуваних, викликів та подолання існуючих і нових кризових явищ», – такий коментар до ситуації дає доцент кафедри біржової діяльності і торгівлі, кандидат економічних наук Яворська В.О..
Група студентів разом з доктором філософських наук, проф. Сторожук С.В. зацікавились питанням ставлення студентів до розповсюдження вірусу, дотримання карантинних вимог. «Я суворо дотримуюся особистої гігієни і карантину... До цього і Вас закликаю, оскільки поки-що рівень загрози для українців невідомий. Багато людей повернулося з країн, де епідемія набула чималого розмаху, тому зараз необхідно особливо обережно контактувати з людьми. Ми не знаємо, хто є носієм вірусу, але кожен має людей, для яких він стане великою загрозою» – наголошує своїм студентам Світлана Володимирівна. Викладачами кафедри філософії гуманітарно-педагогічного факультету було запропоновано написати роботи, де б студенти висловили свої думки щодо поширення вірусу і ситуації, що склалася. Як запобігати, чи насправді все відбувається так, як нам про це розповідають засоби масової інформації в різних куточках України, чому не варто панікувати.. Ці та інші питання та проблеми були розкриті студентами. В багатьох роботах було сказано саме про байдужість людей і невиконання навіть елементарних правил запобігання вірусу. Тому, в домашніх умовах було проведено дослід щодо поширення бактерій. Метою досліду було показати, наскільки важливим є дотримання особистої гігієни, особливо в період карантину.
Відео https://www.youtube.com/watch?v=edcwW0dyqF4&feature=youtu.be
Результати, на яких можемо спостерігати, як поширюються бактерії, показані на фото: 1 день експерименту:

Останній день експерименту:

Сподіваємось, що після цих фото люди відповідальніше будуть ставитись до власної гігієни.
Хочеться попросити, щоб студенти та викладачі не були байдужими до поширення вірусу. Карантин – це не канікули! Уникайте зустрічей в компаніях, виходьте на вулиці тільки за нагальної необхідності, не наражайте на небезпеку себе і своїх близьких. У магазинах дотримуйтесь дистанції не менше 1,5 м, одягайте маску та рукавички. Наразі кожен з нас може бути носієм вірусу і тільки дотримуючись правил, самоізоляції та робочого режиму у власних домівках, ми зможемо зберегти здоров’я і своє, і оточуючих людей.
Навчання, саморозвиток, читання книг, перегляд улюблених фільмів, здоровий сон і харчування, заняття спортом, йогою, музикою…
Самоізоляція – не привід для пригнічення! Просимо кожного ставитись до ситуації, що склалась, відповідально. Мийте руки, навчайтесь вдома та будьте здоровими!
Грабіна Софія
студентка першого курсу
економічного факультету
